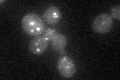
YMR110C
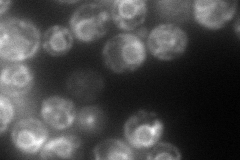
YMR110C
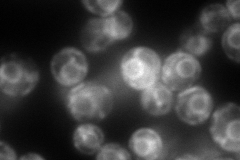
YMR110C
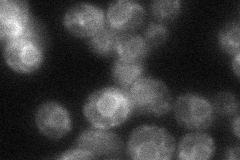
YMR110C

View description
Putative fatty aldehyde dehydrogenase, located in the mitochondrial outer membrane and also in lipid particles; has similarity to human fatty aldehyde dehydrogenase (FALDH) which is implicated in Sjogren-Larsson syndrome
Localization:
Intensity:
Fold change:
Significance:
-
C’ GFP library in SD
punctate27.53 -
N' NOP1pr-GFP in SD
ER112.724 -
N' TEF2pr-mCherry in SD
ER230.906 -
N' NATIVEpr-GFP in SD
ER43.2519 -
N' TEF2pr-VC and Cyto-VN in SD

ER52.8424 -
C’ GFP library in SD+DTT

punctate30.861.12No -
C’ GFP library in SD+H2O2

punctate28.281.02No -
C’ GFP library in Starvation Media

punctateN/AN/AYes -
C’ GFP library on the background of Pup2-DaMP

punctate -
C’ GFP library on the background of CCT mutant

punctate35.65491.29466No
